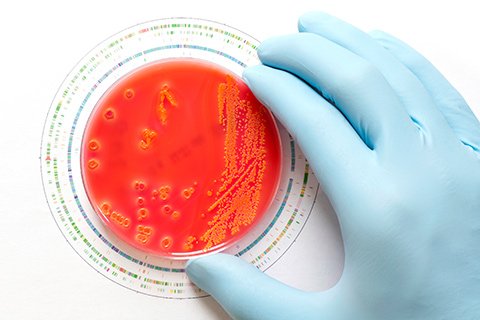

Uudenlainen antibiootti tuo toivoa
antibioottiresistenssi 12.01.2015 12:31 ISTOCKPHOTO
Yhdysvaltalaiset tutkijat ovat löytäneet maaperästä aivan uudentyyppisen antibiootin, jota pidetään käänteentekevänä. Siitä toivotaan apua resistenttien bakteerien nujertamiseen.
Teiksobaktiiniksi nimetty antibiootti on tehonnut hiirikokeissa erilaisiin mikrobeihin, jopa metisilliinille resistenttiin Staphylococcus aureus -bakteeriin (MRSA) sekä antibioottiripulia aiheuttavaan Clostridium difficileen.
Tutkijoiden mukaan on erityisen kiinnostavaa, että bakteerit eivät ole kyenneet kehittämään resistenssiä teiksobaktiinia vastaan. Tällainen lääkeaine olisi heidän mielestään käänteentekevä.
Samaa mieltä on myös suomalaisasiantuntija, professori Jari Yli-Kauhaluoma Helsingin yliopiston farmasian tiedekunnasta. Teiksobaktiini voisi hänestä olla käänteentekevä antibioottikandidaatti kahdestakin syystä.
– Se on peräisin beeta-proteobakteerien pääjaksoon kuuluvasta uudesta bakteerista, jota ei ole aiemmin kasvatettu laboratoriossa. Lisäksi sen tunnettujen sukulaisbakteerien ei ole tiedetty tuottavan antibioottisesti vaikuttavia yhdisteitä. Toiseksi, teiksobaktiini poikkeaa kemialliselta rakenteeltaan merkittävästi tunnettujen antibioottien rakenteista.
Yli-Kauhaluoma kertoo, että teiksobaktiini näyttää tehoavan pelkästään grampositiivisia bakteereita vastaan. Se ei siis tehonne gramnegatiivisiin tauteja aiheuttaviin bakteereihin. Tällaisia ovat esimerkiksi Pseudomonas aeruginosa ja sairaalainfektioita aiheuttava E. coli.
Lääke on valmis 5-6 vuoden kuluttua?
Teiksobaktiini on peräisin maaperässä esiintyvästä, aiemmin tuntemattomasta, bakteerilajista. Alkuperän ei uskota hankaloittavan lääkeaineen kehittämistä tai aiheuttavan erityisiä riskejä lääkkeen käyttäjälle.
– Ovathan monet tälläkin hetkellä käytössä olevista antibiooteista peräisin maanäytteiden bakteereista ja sienistä, Yli-Kauhaluoma huomauttaa.
Koska yhdiste on kemialliselta rakenteeltaan aivan uusi, täytyy sen teho ja turvallisuus varmentaa vielä monin tavoin, esimerkiksi kliinisin kokein. Kuluu vielä vuosia, ennen kuin lääkeaineen sopivuutta voidaan alkaa testata ihmisillä.
– Tyypillisesti lääkkeen kehittäminen kestää vähintään kymmenen vuotta ja vaatii käytännössä satojen miljoonien eurojen suuruisen rahoituksen, Yli-Kauhaluoma sanoo.
Teiksobaktiinin löytäjät uskovat pystyvänsä kehittämään sen lääkkeeksi 5-6 vuoden aikana. Uusi antibiootti tuo toivoa ihmiskunnalle, sillä antibioottiresistenssi pahenee jatkuvasti.
ERJA ELO